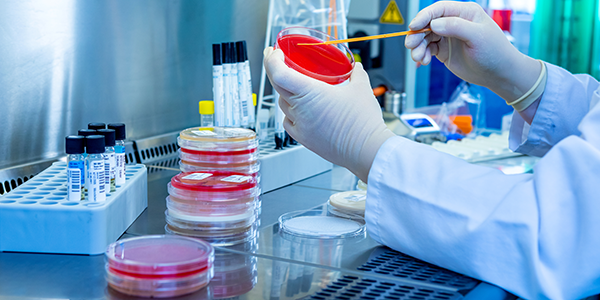
None

Wer wir sind
Wir sind als unabhängiges medizinisches Fachlabor an den Standorten Chemnitz, Dresden, Elsterwerda und Leipzig-Mölbis tätig und bieten das komplette Spektrum der Labormedizin aus einer Hand an. Daneben verfügen wir über eine ausgewiesene Expertise im Bereich der Liquordiagnostik und der Mykologie.
Unsere Laboratorien sind Partner von Ärzten, Krankenhäusern, Firmen und öffentlichen Einrichtungen.